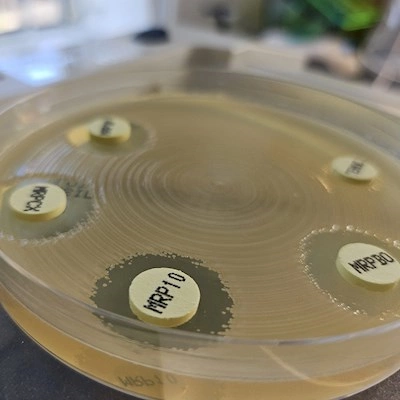
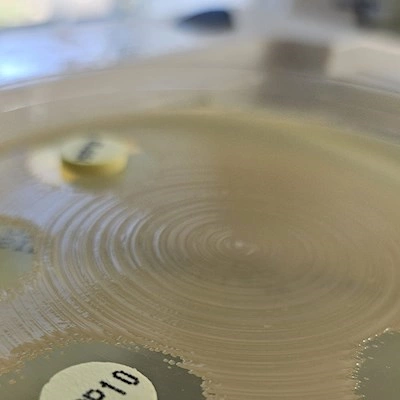

Resistens
Bakterier udvikler kontinuerligt nye resistensmekanismer, og et højt forbrug af antibiotika fremmer denne proces. På Statens Serum Institut overvåger og forsker vi i de forskellige resistensmekanismer.
Vi kan ikke komme uden om, at bakterier udvikler resistens. Men vi kan bremse udviklingen ved kun at give antibiotika, når det er nødvendigt samt begrænse brugen af bredspektrede antibiotika.
Ifølge WHO er resistente bakterier en af de største trusler mod menneskers sundhed. Den udbredte brug af antibiotika har medført udvikling af resistens hos flere bakteriearter, og hvert år dør ifølge Europa Kommissionen cirka 33.000 europæere af infektioner, som skyldes resistente bakterier.
I Danmark overvåger vi en række resistente bakterier samt forsker i deres resistensmekanismer og årsagerne til resistensudvikling.